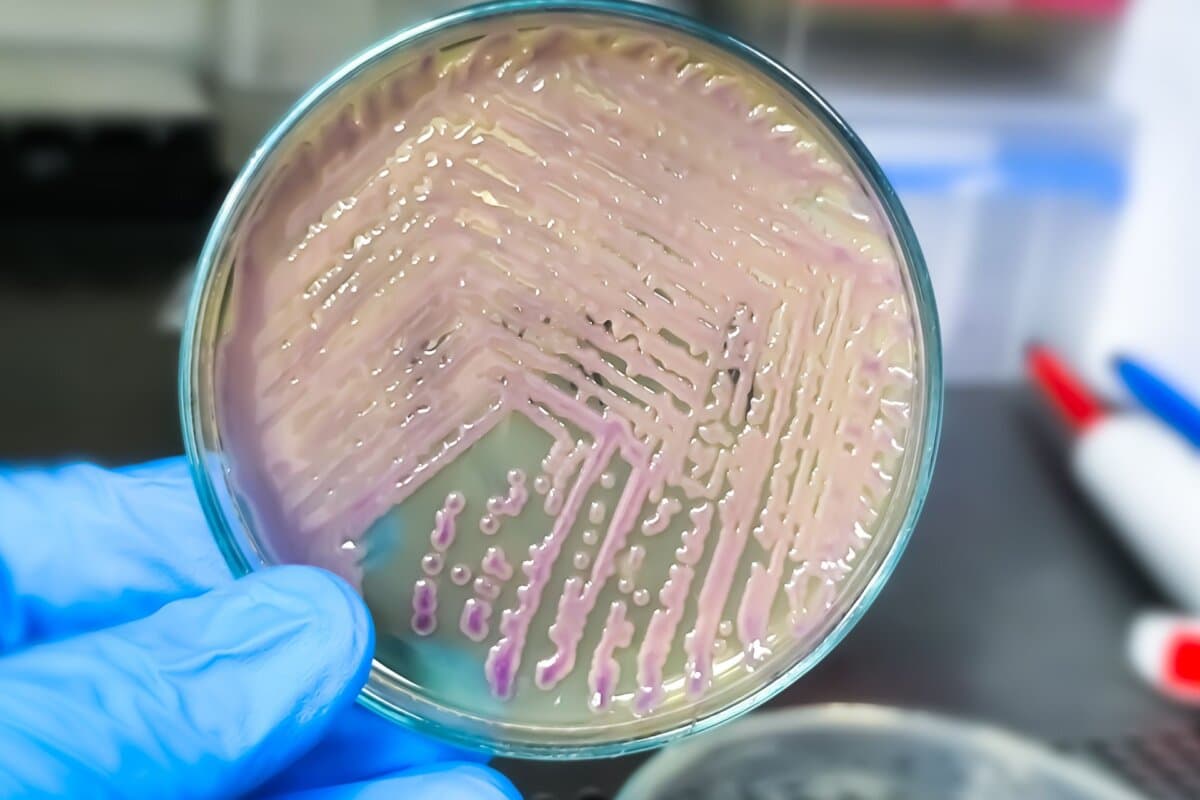
Uropathogene E coli sind die häufigsten Auslöser eines Harnwegsinfektes.

Pathogenetik-Puzzle Harnwegsinfekt
Uropathogene E. coli (UPEC) sind die häufigsten Auslöser eines Harnwegsinfekts. Welche Pathogenitäts- und Fitnessfaktoren diese Darmbakterien ausbilden, was Menschen diesen entgegensetzen können und warum manche Patienten rezidivierende Harnwegsinfekte entwickeln.
Die Pathophysiologie des Harnwegsinfekts (HWI) ist nach wie vor ein Puzzle-Spiel, bei dem noch einige Teile fehlen, sagte Prof. Dr. Sören Schubert, Lehrstuhl für Medizinische Mikrobiologie und Krankenhaushygiene an der LMU München und Mitglied des Leitliniengremiums für urologische Infektionen der European Association of Urology (EAU, 1). In 75 bis 80 Prozent der Fälle sind uropathogene E. coli (UPEC) Auslöser eines HWI.
Was normale E. coli der Darmflora von E. coli als Erreger von HWI unterscheidet? «Uropathogene E. coli sind selbst Opfer einer Infektion geworden», erklärte Prof. Schubert. Sie haben durch die Aufnahme von Viren und anderen mobilen genetischen Elementen grosse Mengen genetischer Informationen erworben. Ähnlich wie beim Anstecken einer externen Festplatte am Computer ermöglichte dies die Ausbildung zahlreicher Pathogenitätsfaktoren und Antibiotikaresistenzen.
Dadurch sind sie insgesamt «fitter» für eine Harnwegsinfektion als «einfache» E. coli aus dem Darm. Zu den Pathogenitätsfaktoren zählen etwa die Beweglichkeit mittels Flagellen, um gegen den Urinstrom anzukommen, und die Fähigkeit der Adhärenz an das Urothel (fimbrielle Adhäsion).
- Update 2024: Blasenentzündungen verstehen, behandeln und vorbeugen. Basel, 11. Juli 2024. Sponsoren: OM Pharma, Labor Dr. Risch.
